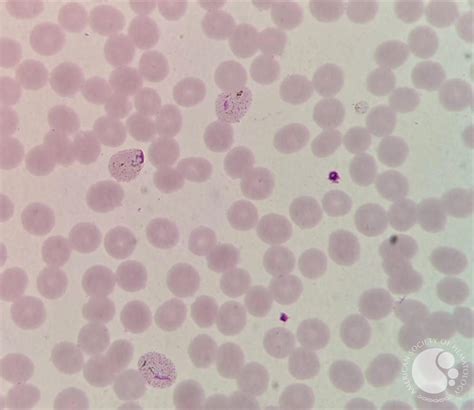

Plasmodium Vivax: Understanding Early Trophozoites
Plasmodium Vivax: Understanding Early Trophozoites
Introduction to Plasmodium Vivax
Alright, guys, let’s dive into the fascinating world of Plasmodium vivax , one of the most widespread human malaria parasites. Specifically, we’re going to zoom in on the early trophozoite stage. Now, Plasmodium vivax is a big deal because it causes a significant amount of malaria cases worldwide, especially outside of Africa. Understanding its lifecycle, particularly the different stages like the early trophozoite, is crucial for effective diagnosis and treatment. So, buckle up as we explore this tiny but mighty parasite and its impact on global health. We will unravel the complexities of Plasmodium vivax , and how it interacts with its human host.
Table of Contents
Plasmodium vivax is distinct from other malaria parasites like Plasmodium falciparum . It has the ability to form dormant stages in the liver, called hypnozoites, which can reactivate and cause relapses weeks, months, or even years after the initial infection. This sneaky behavior makes P. vivax infections particularly challenging to eradicate. The parasite’s lifecycle involves both mosquitoes (the vectors) and humans (the hosts), and it goes through several distinct morphological stages, each with its own characteristics and role in the infection process. We need to understand each stage to figure out how to combat this parasite effectively. From preventing mosquito bites to developing drugs that target all stages of the parasite, including the hypnozoites, our approach must be comprehensive.
Understanding Plasmodium vivax goes beyond just knowing its lifecycle. It also involves considering the geographical distribution of the parasite. P. vivax is most commonly found in Asia, Latin America, and parts of Africa. However, it has a wider distribution than Plasmodium falciparum , the deadliest malaria parasite. This wider distribution is due to P. vivax ’s ability to tolerate lower temperatures and its specific biological characteristics. The adaptability of P. vivax contributes to its persistence and makes it a significant public health concern in various regions. In addition to geographical distribution, factors such as socioeconomic status, access to healthcare, and environmental conditions play a crucial role in the transmission and prevalence of P. vivax malaria. Addressing these factors is essential for implementing effective control strategies and reducing the burden of the disease.
What is a Trophozoite?
So, what exactly is a trophozoite? In the simplest terms, a trophozoite is the active, feeding stage of a protozoan parasite, like Plasmodium vivax . Think of it as the parasite’s main growth phase inside its host. This is when the parasite is busy munching on nutrients, growing larger, and preparing to reproduce. For Plasmodium vivax , the trophozoite stage occurs within the red blood cells of humans. After a mosquito injects sporozoites into the bloodstream, they travel to the liver, mature, and release merozoites. These merozoites then invade red blood cells and transform into trophozoites. Inside the red blood cells, the trophozoites undergo significant morphological and physiological changes. They start as small, compact ring-like structures and gradually develop into larger, more amorphous shapes. This transformation is accompanied by active feeding and metabolism, as the parasite utilizes the host cell’s resources to fuel its growth and replication.
The trophozoite stage is critical for the parasite’s survival and propagation. It is during this stage that the parasite actively contributes to the pathology of malaria. As trophozoites grow and multiply within the red blood cells, they cause damage and ultimately lead to the rupture of the cells, releasing more merozoites to infect additional red blood cells. This cycle of invasion, growth, and rupture is responsible for the characteristic symptoms of malaria, such as fever, chills, and anemia. Furthermore, the trophozoite stage is often the target of antimalarial drugs. Many of these drugs are designed to interfere with the parasite’s metabolism or inhibit its growth and replication within the red blood cells. Therefore, a thorough understanding of the trophozoite stage is essential for developing and implementing effective malaria control strategies. This includes identifying specific vulnerabilities of the trophozoite and designing drugs that specifically target these vulnerabilities.
In addition to its role in the parasite’s lifecycle and the pathology of malaria, the trophozoite stage also has diagnostic significance. Microscopic examination of blood smears is a common method for diagnosing malaria, and trophozoites are often the most readily identifiable stage of the parasite in these smears. The appearance of trophozoites can vary depending on the species of Plasmodium and the stage of development. In Plasmodium vivax infections, trophozoites typically have a characteristic morphology that helps distinguish them from other malaria parasites. Therefore, being able to accurately identify trophozoites in blood smears is a crucial skill for healthcare professionals involved in malaria diagnosis and treatment. This requires expertise in microscopy and a thorough understanding of the morphological features of different Plasmodium species.
Characteristics of Early Plasmodium Vivax Trophozoites
Okay, let’s get specific. What does an early Plasmodium vivax trophozoite look like? These young trophozoites typically appear as small rings inside the red blood cells. Think of it as a tiny signet ring. The ring is made up of the parasite’s cytoplasm, and it surrounds a clear vacuole. The nucleus is usually visible as a small dot on the ring. These early forms are often referred to as